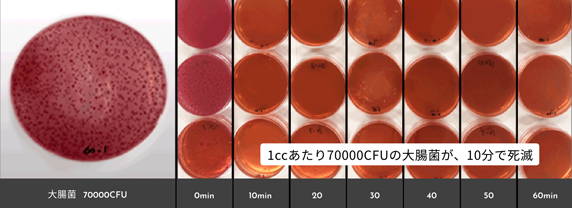

Products商品情報
美容に関心のあるあなたへミラブルzero

紡のバスルーム施工では株式会社サイエンス製のシャワーヘッド
「ミラブルzero」を取り付けることが可能です。
美容に優れたミラブルzeroの特徴を紹介させていただきます。
ミラブル zero
ミラブル zeroとは、毛穴の奥にまで届くウルトラファインバブルを生成するシャワーヘッドです。
ウルトラファインバブルを含んだ洗浄力の高い超微細空気混合水を作り出し、シルクに包み込まれるような上質な肌感触を実現します。
バブルを含むミスト水流と、勢いのあるストレート水流をワンタッチで切り替えて使え、ストレートシャワーでは湯冷めしにくい保温効果が実証されています。
さらには塩素の削減、節水効果も認められ、美容にも環境にも優しい新次元のシャワーヘッドです。

ウルトラファインバブルとは
ウルトラファインバブルとは、直径1μm未満の泡の事で、マイクロバブルよりさらに小さく、非常にすぐれた洗浄力を持ちます。
ミラブルzeroのシャワーヘッドは1つの吐出口あたり、1秒間に約2000回転(1分間に約12万回)の高速うず流でウルトラファインバブルを生成。
さらに水流が吐出する際、外気を巻き込む機構により、安定して気泡を発生することができます。
普段どおりにシャワーを浴びているだけで、ウルトラファインバブルが毛穴やシワの間に入り、汚れを吸着してきれいに洗い流してくれます。

安定して気泡を発生することが出来る特殊フィン
特殊なフィンにより、外気を水流に混合させ
直径約30㎛のマイクロバブルを、約6,000個/cc発生させます。
ストレートでも特許を取得済の洗浄力
ゆで卵を作って殻をむき、ミラブルキッチンのミストで洗った後、表面を乾かしてから使用。
ゆで卵の表面にラー油を塗布し、ミラブルゼロ・ノーマル吐水シャワーそれぞれから毎分7Lの流量の水を吐出。
室温:26.8℃ 湿度:35% 水温:15.9℃

4つの特徴
うるおい効果
ミラブルzeroを使用した後の肌の水分量を測定。
ミラブルzero使用後は使用前と比較して肌の水分量がアップ。
お湯が肌に浸透して潤うことがわかりました。
保温効果
ミラブルzeroを使用した後の肌の表面温度を測定。
ミラブルzeroでは大きく肌表面の温度が上昇している事がわかりました。
ストレート水流のシャワーだけで体が温まり、湯冷めがしにくいことがわかります。
脱塩素効果
トルネードスティックに搭載された亜硫酸カルシウムフィルターにより、水道水中の残留塩素を低減。
水道水の塩素を約80%低減することができ、肌への塩素刺激を抑えたやさしいシャワーへと進化しました。
普段の生活の中で肌を労ることができます。
節水効果
特殊な「空気混合方式」を採用することで、同じ水圧でも水の使用量を大幅に節約します。
ストレート水流で約25%、ミスト水流では約60%の節水に成功しています。
美容だけでなく、環境にも経済的にも優しいシャワーヘッドです。
ミラバス

紡のバスルーム施工では株式会社サイエンス製の「ミラバス」を取り付けることが可能です。
美容と健康に優れたミラバスの特徴を紹介させていただきます。
ミラバス
「ミラバス」は毛穴の奥まで届くマイクロバブル※(超微細)を生成し、ただお湯に浸かるだけでミクロの泡がお肌の老廃物を優しく取り除き、健康的でつややかな美肌にします。
さらに、入浴後はボタン一つで浴槽壁面の汚れや配管汚れを分解・除菌・脱臭する「マイクロイオニー」を搭載。
人も浴室も美しく保ちます。

マイクロイオニー
ミラバスは、洗浄ボタンを押すだけで、マイクロバブル化した低温プラズマ発生体=マイクロイオニーを発生。
このマイクロイオニーは様々な物質との高い反応性を持つため、浴槽壁面の汚れなどの分解・殺菌・脱臭に効果が期待できます。
ファインバブル専業メーカーならではの独自技術「マイクロイオニー」の搭載によって、ミラバスはマイクロバブルによる身体の洗浄と心地よい入浴だけでなく、
衛生的な入浴環境の維持まで容易にしています。

1ccに約12,000個の水と空気でできた超微細な泡が、肌のすみずみまでの汚れや毛穴の奥の老廃物などを吸着して取り除くほか、気になる臭いの元もかき出して洗い流します。
身体中の毛穴に入り込んだ超微細な気泡が弾ける時にほどよい刺激を与えてくれるので身体の芯から温まり、お風呂上がりに湯冷めしにくく、毎日温泉に入ったような気分が味わえます。
大腸菌を用いたマイクロイオニーの反応試験
(減衰効果)
1cc当たり約70000CFU※1の大腸菌にマイクロイオニーを与えて経過を観察。約10分後には、全ての大腸菌が死滅し、菌体に対してのマイクロイオニーの効果が充分期待出来る結果となりました。
※1:CFU(Colony forming unit)=コロニー形成単位。まいた微生物中に含まれる増殖可能な微生物細胞の数を示す単位として用いられます。*空気ファインバブル(低温プラズマ発生体を持たないファインバブル)においては50%程度の減衰が確認されましたが、現状効果に関しては未確認要素もあり、正確性の高いデータをを得るため研究を継続中です。
マイクロバブルの汚れ落ちテスト
身体をゴシゴシこすらなくても、ただお湯に身を委ねているだけで、ミクロの泡がお肌の汚れを取り除き、健康的でつややかな美肌にしてくれます。



